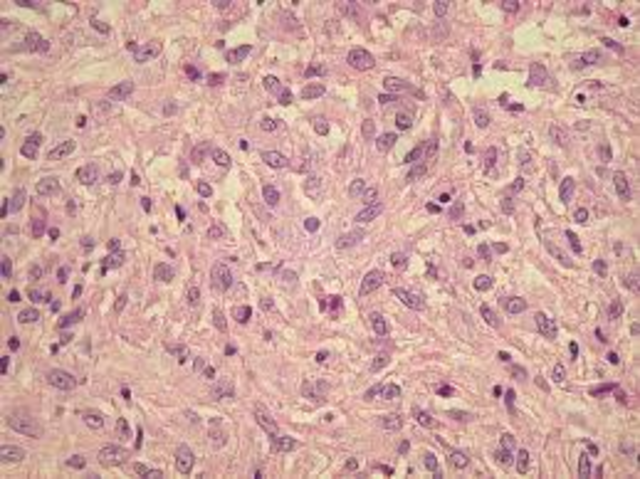
Virchow

-
Hooke found the cell in 1653. Hooke's method was looking at a thin slice of cork through a microscope at 50x. Hooke only saw the cell walls as dead tissue. He called them "cells" for the individual compartments that he saw.
-
In 1670, Leeuwenhoek looks at pond water with his own microscope he created lenses for. He discovered the "protozoa" a single celled organism and called them "animalcules". He also discovered the first bacteria. Leeuwenhoek built off of Hooke's theory.
-
Robert Brown introduced his first paper oBrown discovered the nucleus in a plant cell. He proposes that all plant tissue are composed off cells. Brrown did not realize that the cell nucleus was present in cells other than plants. He studied the way plants grow to things like how their cells work together. This is the first discovery of the nucleus.
-
Schledien followed through with Browns theory on plant tissue being composed of cells but he added that cells are the basic building blocks of all plants. Schleiden stated that plants grew by adding new cells. He later exteneded his theory to aninals tissue.
-
Theodor Schwann proposed 3 generalizations dealing with cells... First, animals and plants consist of the makeup of cells. Second, the cells have independent lives which, third are subject to the lives of organisms. Once he finished observing he soon realized the view point that all tissue are made up of cells and laid the foundation for the cell theory. He also discovered the enzyme pepsin and worked on fermentation, thus creating his cell theory.
-
Virchow states that all cells resulted from the division of previous cells. He also introduced cell pathology, saying that diseases do not affect the entire organism just certain groups of the cells making it easier to treat illnesses.
A list shows items. A timeline shows sequence.
Use Timetoast to make dates, milestones, and turning points easier to understand in a clear visual format. Timetoast is a timeline maker for work, school, research, and stories.